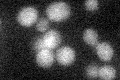
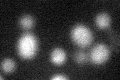

View description
Protein required for nuclear membrane fusion during karyogamy, localizes to the membrane with a soluble portion in the endoplasmic reticulum lumen, may form a complex with Jem1p and Kar2p; expression of the gene is regulated by pheromone
Localization:
Intensity:
Fold change:
Significance:
-
C’ GFP library in SD
below threshold14.73 -
N' NOP1pr-GFP in SD

below threshold14.5523 -
N' TEF2pr-mCherry in SD

below threshold5.21892 -
N' NATIVEpr-GFP in SD

below threshold15.73 -
N' TEF2pr-VC and Cyto-VN in SD

#N/A0 -
C’ GFP library in SD+DTT
cytosol15.121.02No -
C’ GFP library in SD+H2O2

cytosol14.60.99No -
C’ GFP library in Starvation Media

cytosol17.141.16No -
C’ GFP library on the background of Pup2-DaMP

below threshold -
C’ GFP library on the background of CCT mutant

below threshold15.6281.0603No
